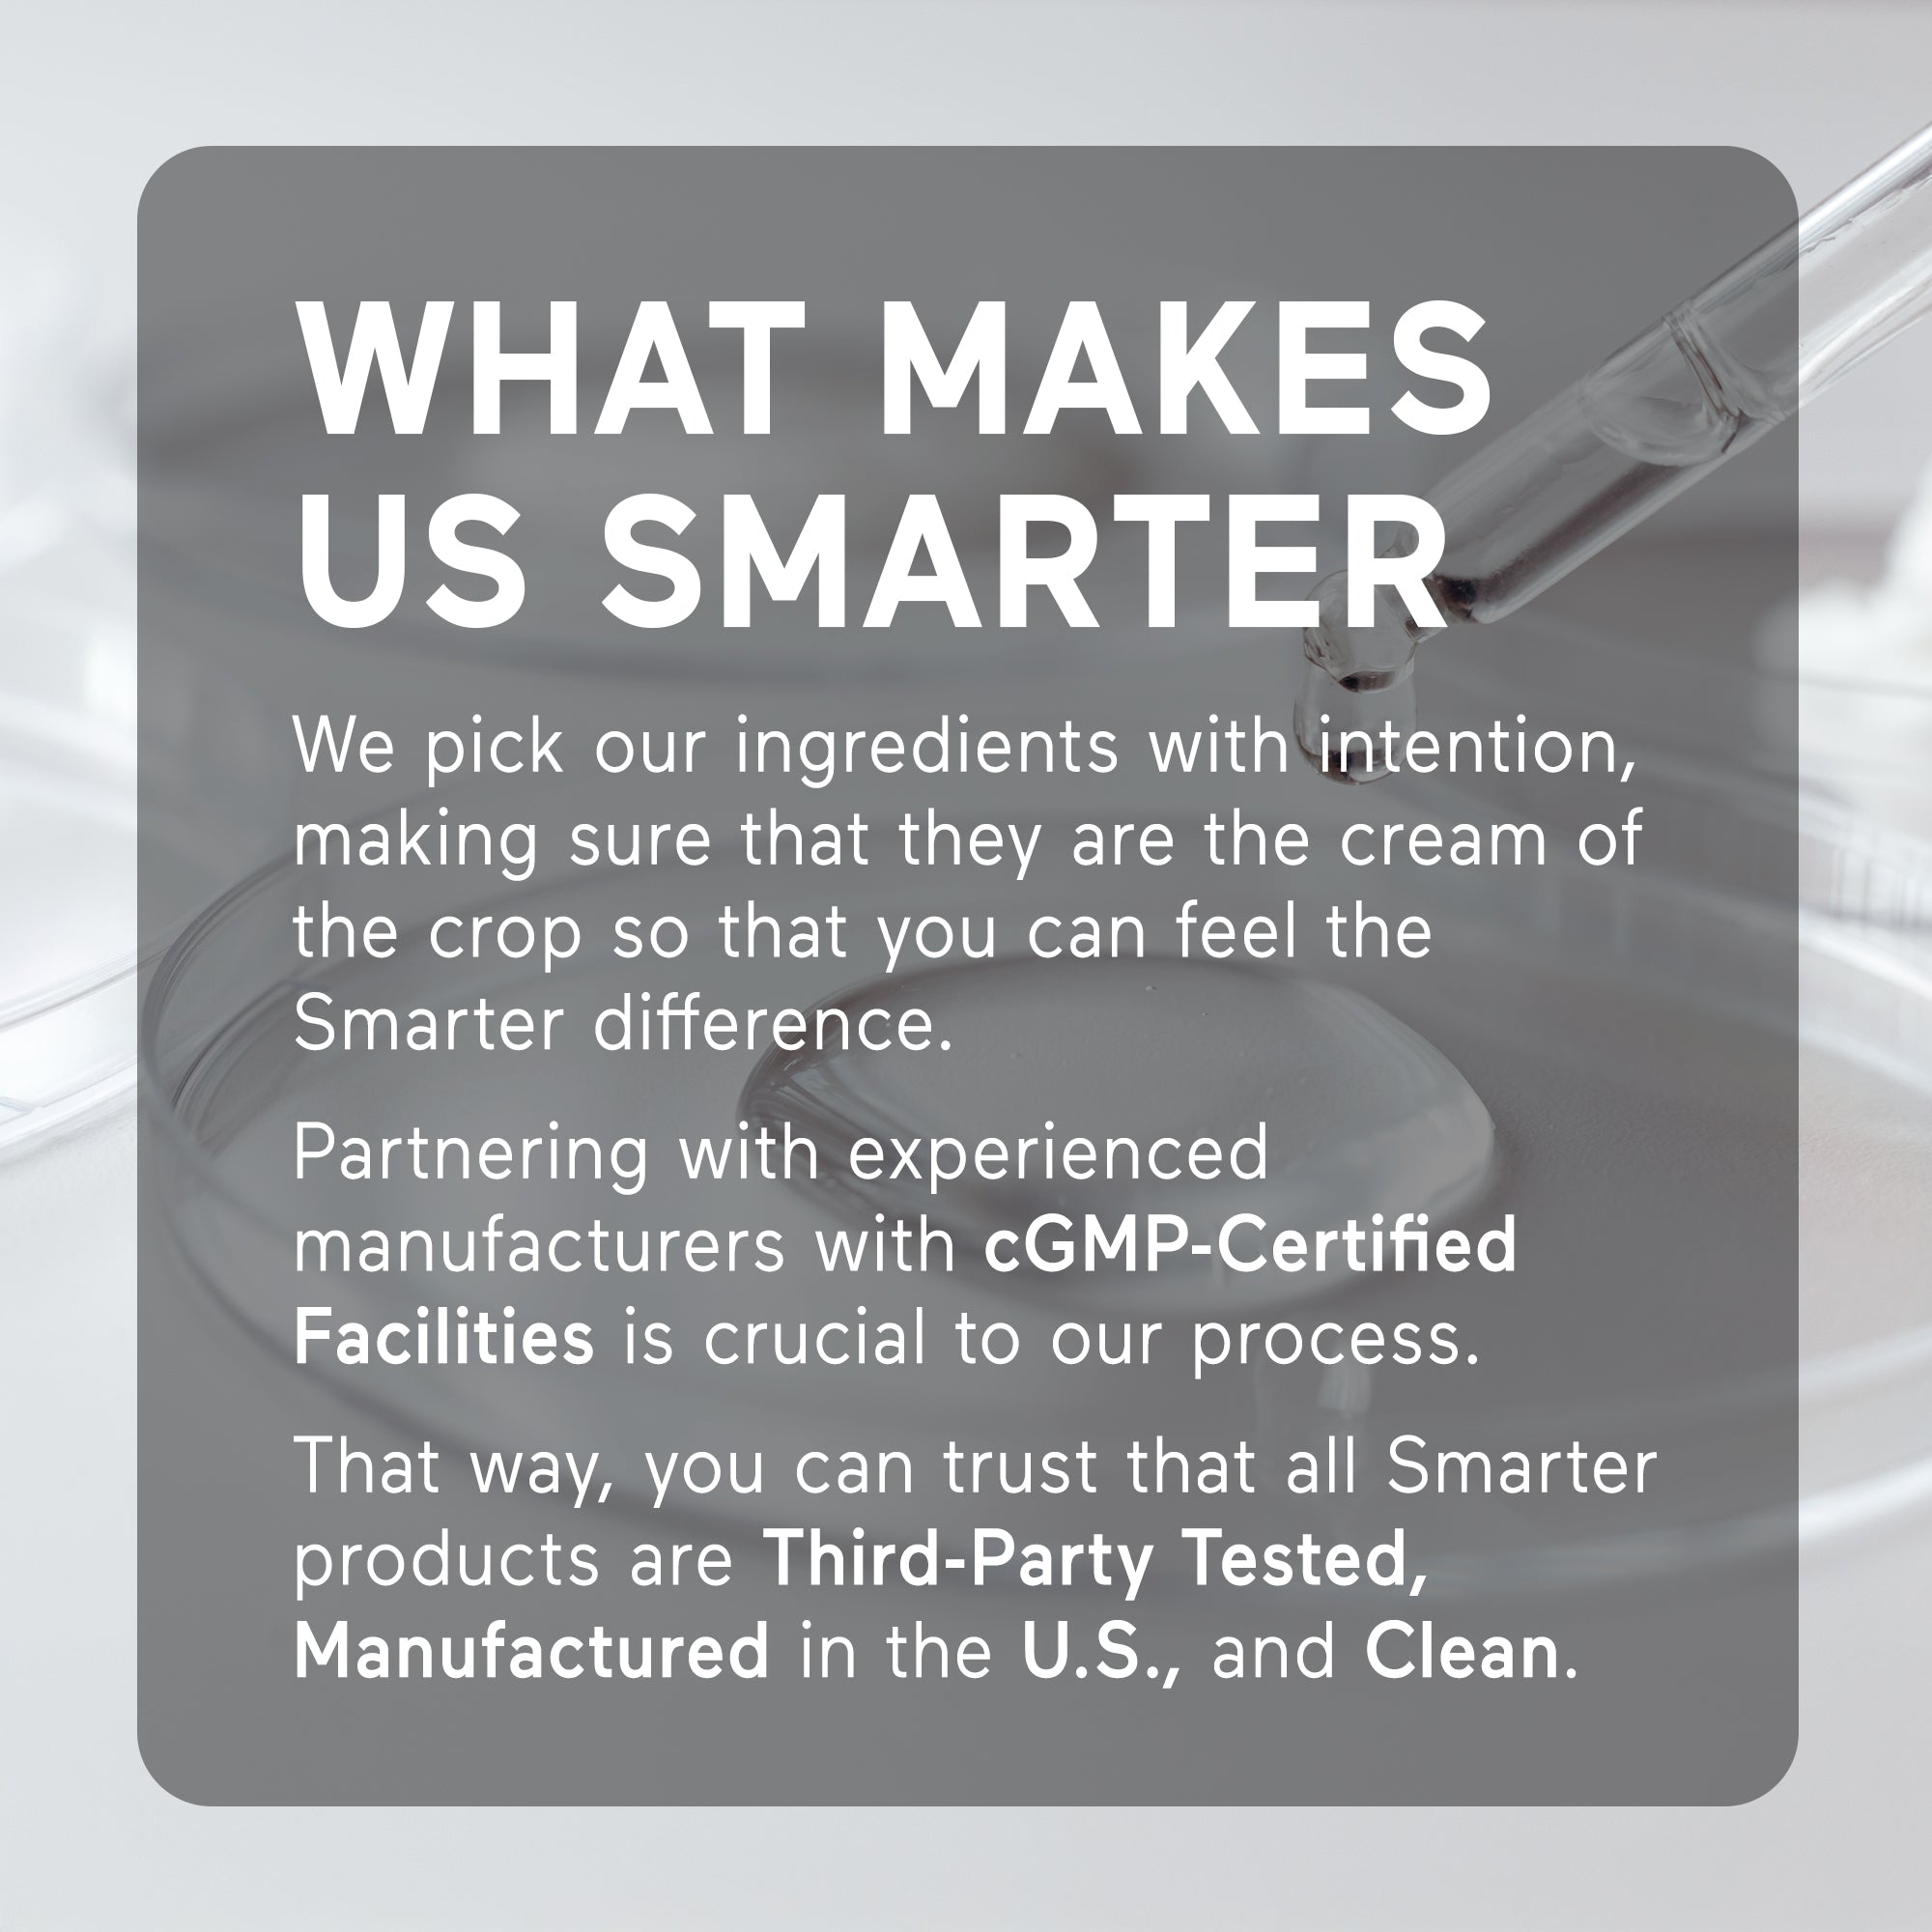
Creatine Monohydrate Capsules

Creatine Monohydrate Capsules
5.0Subscribe to save:
100% No Risk Money Back Guarantee
*These statements have not been evaluated by the Food and Drug Administration. This product is not intended to diagnose, treat, cure, or prevent any disease.
Product Facts
- 2.5 g of creatine per serving
- Vegan
- Pure creatine monohydrate
- Third-Party tested
- Manufactured in the USA
- Non-GMO
- Gluten Free

Clean, Convenient Creatine
Most creatine supplements come as powders, but Smarter provided a convenient, mess-free alternative. These creatine capsules are a great way to take creatine on the go, without having to mix it into any beverage.
What's In It?

Creatine monohydrate



Creatine

Creatine
Vegan Capsule


Vegan Capsule

How to Take Creatine Pills

How to Take Creatine Pills
Smarter is Clean
You deserve to trust what goes into your body, and we aim to honor that trust. Smarter Nutrition uses clean ingredients that are third-party tested, gluten free, non-GMO and manufactured in the USA.
Third-Party Tested
Gluten Free
Manufactured in the USA
Non-GMO
Clean Ingredients



